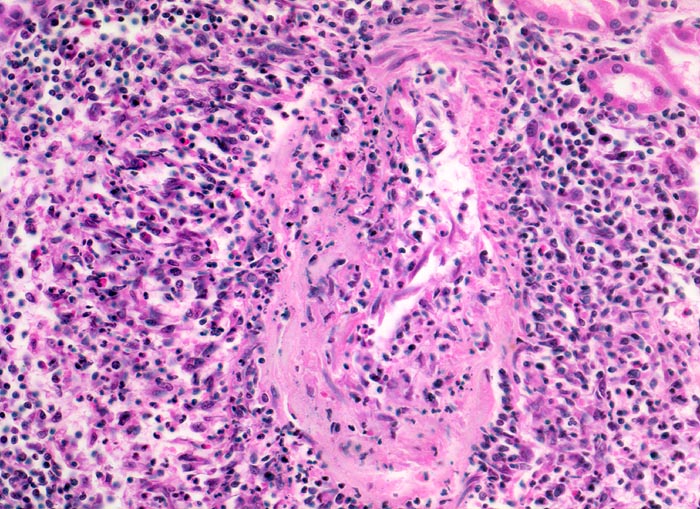

PathoPic – image database / PathoPic ID 4249 - Polyarteritis nodosa Makroform: akute Phase
de
Diagnose
Polyarteritis nodosa Makroform: akute Phase
Diagnose Gruppe
Systemerkrankung/Immunpathologie
Topographie
Niere
Topographie Gruppe
Niere, Harnwege
Beschreibung
Mittelgrosse Arterie mit einer nicht ganz frischen fast zirkulären Gefässwandnekrose. Nur ein kleiner Gefässwandabschnitt lässt noch eine Muskelschicht erkennen. Entsprechend der fast zirkulären Nekrose ist das ganze Gefäss mantelförmig umgeben von einem gemischten Entzündungsinfiltrat (neutrophile und eosinophile Granulozyten, Lymphozyten, Plasmazellen und Histiozyten). Stellenweise greift das Entzündungsinfiltrat auch auf die Gefässwand über.
Zusatzbefund
Makroskopischer Befund der Nieren: Vergrösserte Nieren mit Petechien und mehreren frischen, teils hämorrhagischen Infarkten.
Klinik
Seit einigen Wochen Fieber unklarer Ätiologie, Gewichtsverlust und Anämie. Im Rahmen der Abklärungen erstmals festgestellte arterielle Hypertonie. Der Patient verstirbt an einem Myokardinfarkt.
Bilder Typ
Histologie
Vergrösserung
200
Alter
64
Geschlecht
unbekannt
Datum
Ersteintrag: 02.07.2002
Update: 04.02.2024